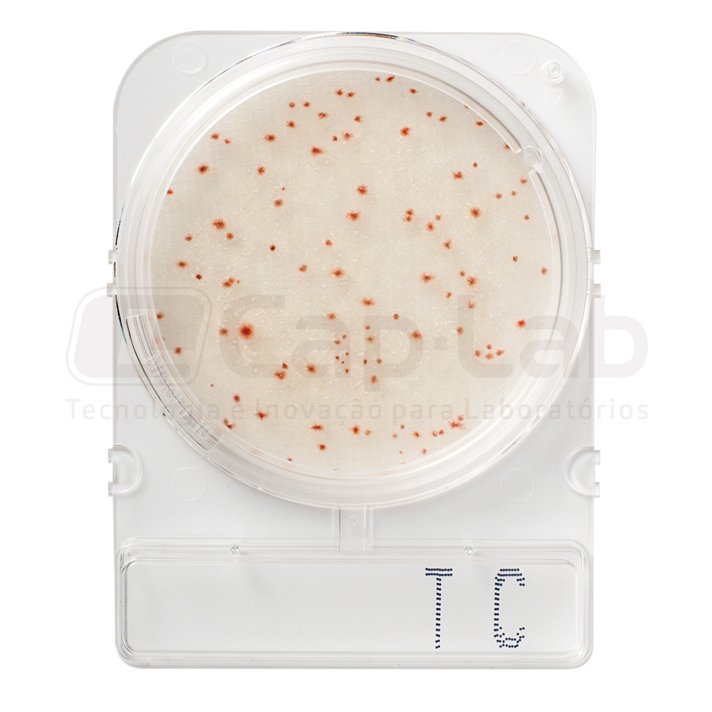

Compact Dry TC
Bactérias totais
Incubação: 48 ± 3h
Temperatura: 35 ± 2°C
Descrição:
Compact Dry é um procedimento simples e seguro para determinar e quantificar microorganismos em produtos alimentícios, cosméticos e outras matérias-primas, incluindo produtos farmacêuticos. As placas cromogênicas Compact Dry prontas para uso são adequadas para os controles a serem realizados durante o processo e para o produto final.
Graças a indicadores redox e substratos cromogênicos, as colônias bacterianas crescem em cores específicas, podendo assim distinguir e identificar com facilidade. Para estudos adicionais, colônias específicas podem ser facilmente removidas separadamente.
As colônias aeróbicas apresentam coloração vermelha, devido ao sal tetrazol (indicador redox), podendo distinguir com muita facilidade dos restos alimentares possíveis.
Especificações:
| Matriz: | Exposições de alimentos e superfícies |
| Tempo de incubação: | 48 ± 3h |
| Temperatura de incubação: | 35 ± 2 °C |
| Embalagem: | 40 e 100 placas |
Modo de uso:
- Retirar a tampa.
- Coloque 1 ml da amostra no centro da superfície da placa Compact Dry.
- A amostra é automaticamente dispersa de forma homogênea e hidrata a camada de meio de cultura, transformando-o em gel em poucos segundos.
- Tampe a placa novamente e inicie a incubação invertida.
Interpretação de resultados:
O meio consiste em um meio não seletivo com um indicador redox de cloreto de 2,3,5-tripenil tetrazólio (TTC). As colônias cultivadas no Compact Dry TC são quase todas de cor vermelha. Como alguns microorganismos podem não reduzir o TTC para desenvolver a cor vermelho / rosa, o Compact Dry TC pode desenvolver colônias que não são necessariamente vermelho claro.
As colônias vermelhas, juntamente com as de outras cores, dão a contagem total.
Armazenamento e prazo de validade:
- Manter em temperatura ambiente, de 1 a 30ºC.
- 18 meses de validade.